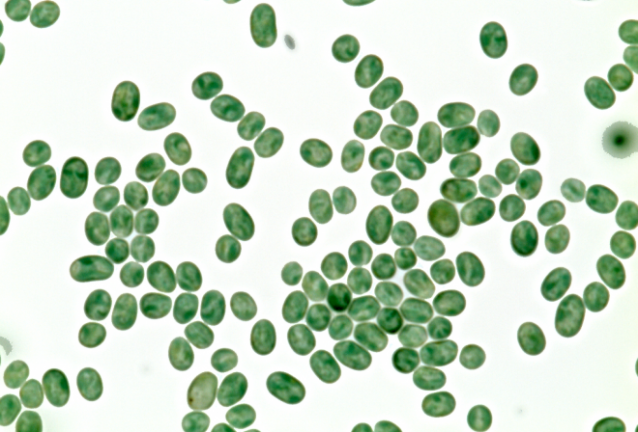

Повече от 300 години учените изследват цианобактериите. И едва сега те успяха да открият, че тези бактерии са способни да виждат. Учените, които са забелязали, че клетките на бактериите приличат на микроскопична очна ябълка или обектив на малък фотоапарат, са от университетите Фрайбург и Кралица Мария, съобщава Zee News.
Цианобактериите се срещат в огромни количества във водоемите, те могат да образуват също мазен зелен слой по скалите и камъчетата. Специалистите изучавали Synechocystis – вид цианобактерии, обитаващи пресноводните езера и реки.
Цианобактериите евоюлирали около преди 2,7 милиарда години. Фактът, че те са способни да произвеждат кислород и да улавят въглеродния двуокис, използвайки слънчевата енергия, вероятно станал причина за масовото измиране през най-стария от известните ледникови периоди.
Новото изследване показало, че тялото на клетките работи като леща. Когато светлината попада върху сферичната повърхност, тя се пречупва и се оказва в другата част на клетката. Това кара бактерията да се движи към светлината с помощта на появяващите сe за няколко минути пипалца. Те се закрепват за повърхността и придържат бактерията.
Клетката Synechocystis е около половин милиард пъти по-малка от човешкото око.

Коментари